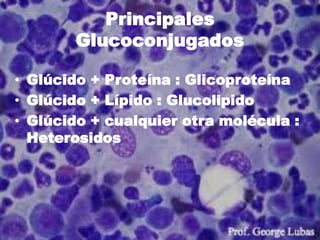
Principales
       Glucoconjugados

• Glúcido + Proteína : Glicoproteína
• Glúcido + Lípido : Glucolipido
• Glúcido + cualquier otra molécula :
  Heterosidos

Este documento define y clasifica los glúcidos. Explica que los glúcidos son biomoléculas formadas por carbono, hidrógeno y oxígeno que pueden ser monosacáridos, oligosacáridos o polisacáridos dependiendo del número de monosacáridos que los componen. Describe los principales tipos de monosacáridos como las triosas, tetrosas, pentosas y hexosas y explica los disacáridos más comunes como la sacarosa, lactosa y maltosa. Finalmente, se